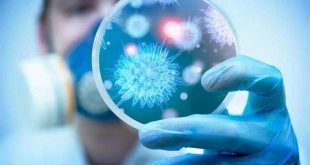
Pics corona

Le Premier ministre Hassan Diab a rencontré lundi le doyen du Corps consulaire honoraire au Liban, Joseph Habis, en présence des membres du corps consulaire. Il a déclaré que le gouvernement porte entre ses mains une “boule de feu”, notant que les prochains jours seront témoins d’une décision importante, un ... Read More »
Coronavirus : 6 morts aux États-Unis
En Chine, le nombre de cas détectés quotidiennement faiblit. L’Italie reste le principal foyer de l’épidémie en Europe, avec plus de 2 000 cas et 52 morts. Quatre nouveaux décès liés au coronavirus ont été enregistrés sur le territoire américain, portant le total à six, tous survenus dans l’Etat de Washington, a indiqué ... Read More »
La ministre Abdel Samad: La responsabilité nationale requiert la prudence des médias dans le dossier Corona et l’adoption des informations officielles
La ministre de l’Information, Manale Abdel Samad, a déclaré ce lundi dans un communiqué, que la responsabilité nationale exigeait une prudence de la part des médias en ce qui concerne la diffusion des nouvelles sur le coronavirus. “Depuis que le premier cas a été détecté au Liban, nous nous sommes ... Read More »
Coronavirus dans le monde : le seuil des 3000 morts dépassé ce lundi et le salon Livre Paris annulé en raison de l’épidémie
Le bilan de l’épidémie de nouveau coronavirus a dépassé lundi les 3000 morts dans le monde et continue d’avoir de sérieuses conséquences partout à travers la planète, notamment en Italie où le nombre de cas explose et en France où le musée du Louvre a fermé. En Chine, les autorités ... Read More »
Réunion des ministres arabes de l’Intérieur à Tunis : Fahmi transmet “les préoccupations des Libanais”
Le conseil des ministres arabes de l’Intérieur s’est réuni ce dimanche en Tunisie et a tenu sa 37ème session pour discuter et adopter des stratégies pour surmonter les défis sécuritaires régionaux auxquels la région fait face actuellement, notamment le terrorisme, la cybercriminialité, le trafic de drogues, l’immigration illicite, et tous ... Read More »
Le pape renonce à un déplacement en raison d’un «rhume»
Le pape François a déclaré dimanche 1er mars renoncer à un déplacement avec la Curie en raison d’un «rhume». «Malheureusement, un rhume me contraint à ne pas participer cette année» à cette retraite de Carême, a-t-il déclaré dimanche à l’issue de la prière de l’Angelus, prononcée sur la place Saint-Pierre ... Read More »
Corée du Nord : Pyongyang tire deux projectiles non identifiés
Ces tirs interviennent quelques semaines après l’annonce par Pyongyang de la fin de son moratoire sur les essais de missiles balistiques de longue portée. Lundi 2 mars, la Corée du Nord a tiré deux projectiles non identifiés, quelques semaines après l’annonce par Pyongyang de la fin de son moratoire sur les essais de ... Read More »
Citroën lance Ami, une voiturette électrique et sans permis à petit prix
Citroën a révélé le 27 février un nouveau modèle de voiture électrique nommé Ami. Avec un prix sous la barre des 10 000 euros, la marque du groupe PSA veut séduire un public plus jeune et citadin. Citroën, deuxième marque historique de SPA, a présenté jeudi 27 février un nouveau modèle ... Read More »
Un représentant japonais au Liban pour discuter du cas Ghosn
Le ministre adjoint de la Justice japonais va se rendre au Liban pour tenter de convaincre les autorités que l’ancien patron de Nissan Carlos Ghosn, qui a fui au Liban en décembre dernier, doit être jugé au Japon, a annoncé vendredi le gouvernement japonais. Dans un communiqué, le ministère japonais ... Read More »
Pourquoi les insectes ne sont-ils toujours pas dans nos assiettes?
Ils sont présents au Salon de l’agriculture depuis 2018, mais dans notre alimentation, on les cherche encore! – Il y a deux ans, les insectes faisaient leur entrée au célèbre Salon de l’Agriculture, via l’une des nombreuses start-up qui rêvent de faire fortune dans l’élevage et la vente de cette “alimentation de demain”. On ... Read More »
 Ministère libanais de l’Information
Ministère libanais de l’Information